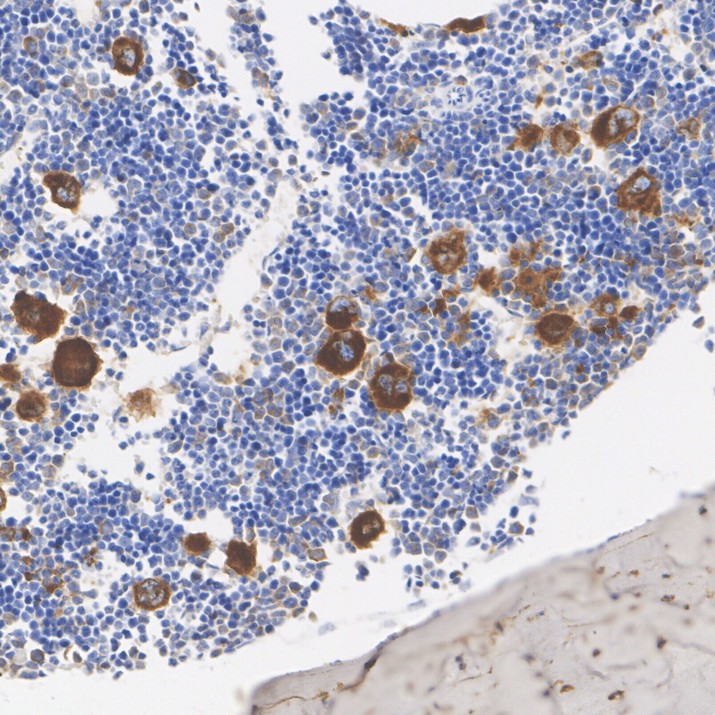

TGF beta 1 Recombinant Rabbit Monoclonal Antibody [PSH18-59] - BSA and Azide free
Catalog# HA751683
TGF beta 1 Recombinant Rabbit Monoclonal Antibody [PSH18-59] - BSA and Azide free
Application
-
WB
-
IF-Cell
-
IHC-P
-
FC
Reactivity
-
Human
-
Mouse
-
Green monkey
With BSA and Azide
-
HA724012
含抗保成分
Conjugation
-
unconjugated